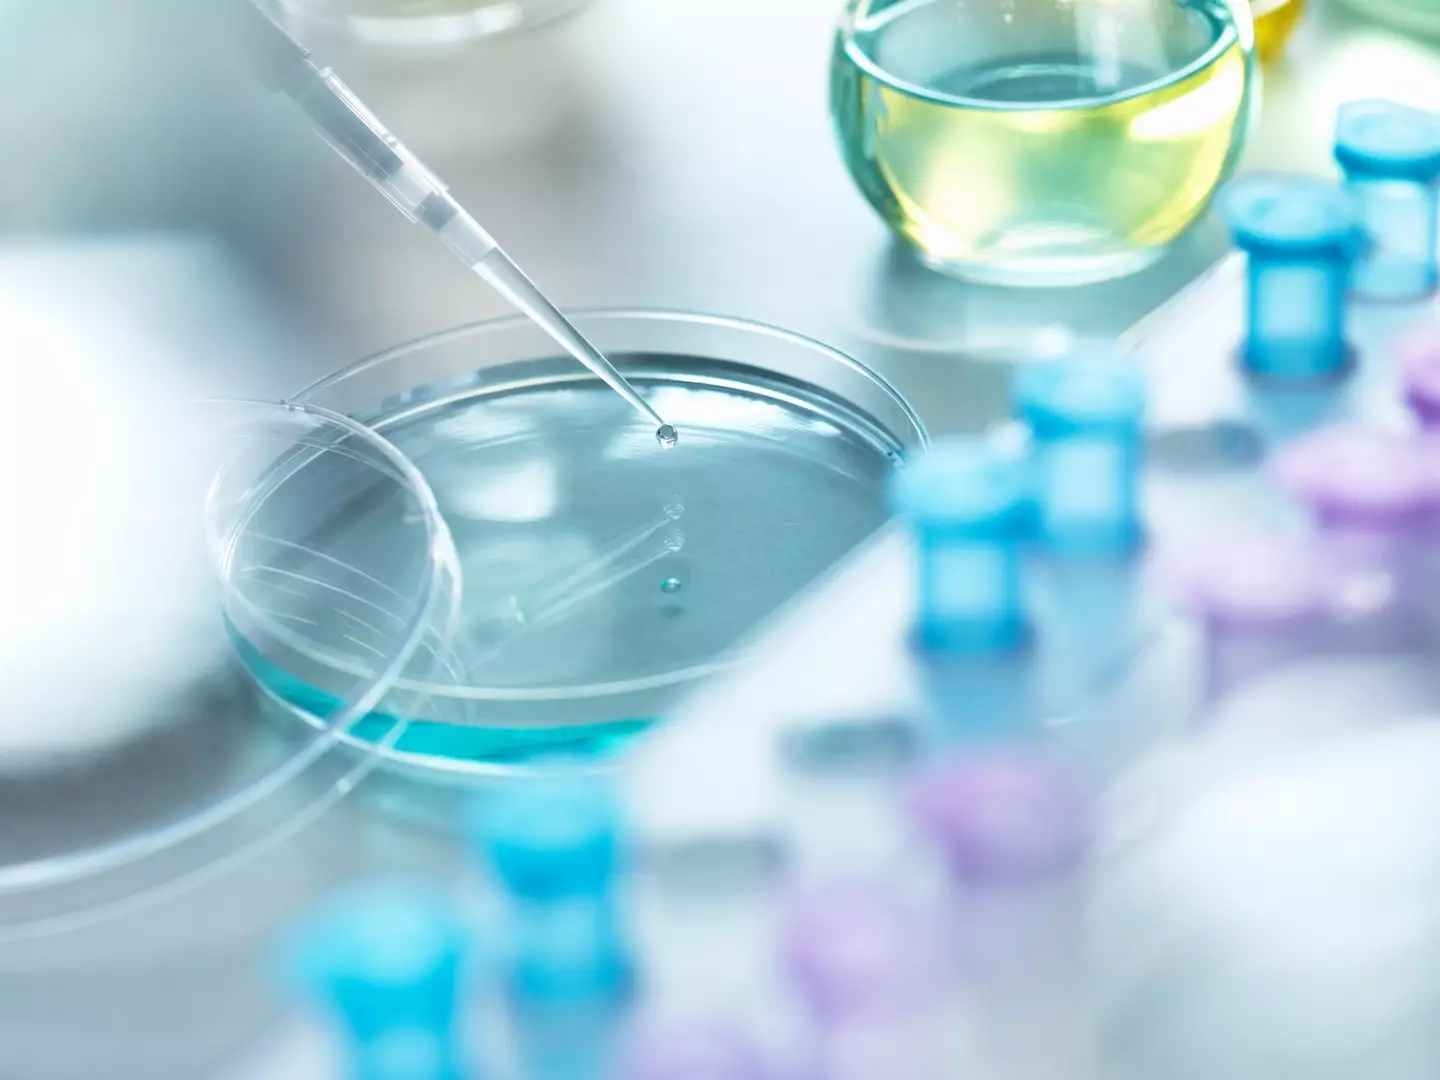

If you’ve ever wondered how organisms can continue to function despite succumbing to death then you’re in luck because scientists may have discovered the answer.
According to researchers, there could very well be a ‘third state’ of existence nestled between life and death that could contribute to the reasoning why our cells and organs continue to work despite our demise.
The idea sounds like something fresh from the pages of Mary Shelley’s Frankenstein, right?

Advert
But according to a new study published in the Physiology journal, the ‘third state’ is where cells gain new capabilities that they did not possess in life.
Moreover, these cells can survive and thrive even if the organism itself dies.
Speaking to The Conversation about their findings, study leads Professor Peter Noble at the University of Washington, Seattle, and Alex Pozhitkov at City of Hope National Medical Center, Duarte, California, said: “Life and death are traditionally viewed as opposites.
“But the emergence of new multicellular life-forms from the cells of a dead organism introduces a 'third state' that lies beyond the traditional boundaries of life and death.”
They added: “Certain cells - when provided with nutrients, oxygen, bioelectricity or biochemical cues - have the capacity to transform into multicellular organisms with new functions after death.”
Advert
To uncover this apparent ‘third state’ of existence, the experts reassessed a handful of studies to investigate whether cells could exist in new forms after an organism had died.
A 2021 study found that when the skin of a dead frog was placed in a petri dish, it started to use small, hair-like structures called cilia to navigate its surroundings.

Scientists found similar results when observing human lung cells, claiming they were able to re-assemble and repair themselves.
These cells have been dubbed 'anthrobots' and their lifespan is thought to be limited, as per Metro.
Advert
According to the study leads, these two examples are a way of highlighting how cells can adapt and survive following an organism’s death.
But how do these cells survive without its host body?
The team claim one of their hypothesis is that ‘specialised channels and pumps embedded in the outer membranes of cells serve as intricate electrical circuits’.
“These channels and pumps generate electrical signals that allow cells to communicate with each other and execute specific functions such as growth and movement, shaping the structure of the organism they form,” they continued.
Advert
It’s understood that this research could eventually ‘redefine death’ as well as have the potential to ‘transform regenerative medicine’.
However, they added that ‘metabolic activity plays an important role in whether cells can continue to survive and function’.
Factors such as species type and sex can all determine whether or not the cell can exist in the so-called third state.
And while much more research is needed to gain a more accurate picture, we can’t say that it isn’t exciting. What a breakthrough, right?
Topics: Science, Health, World News